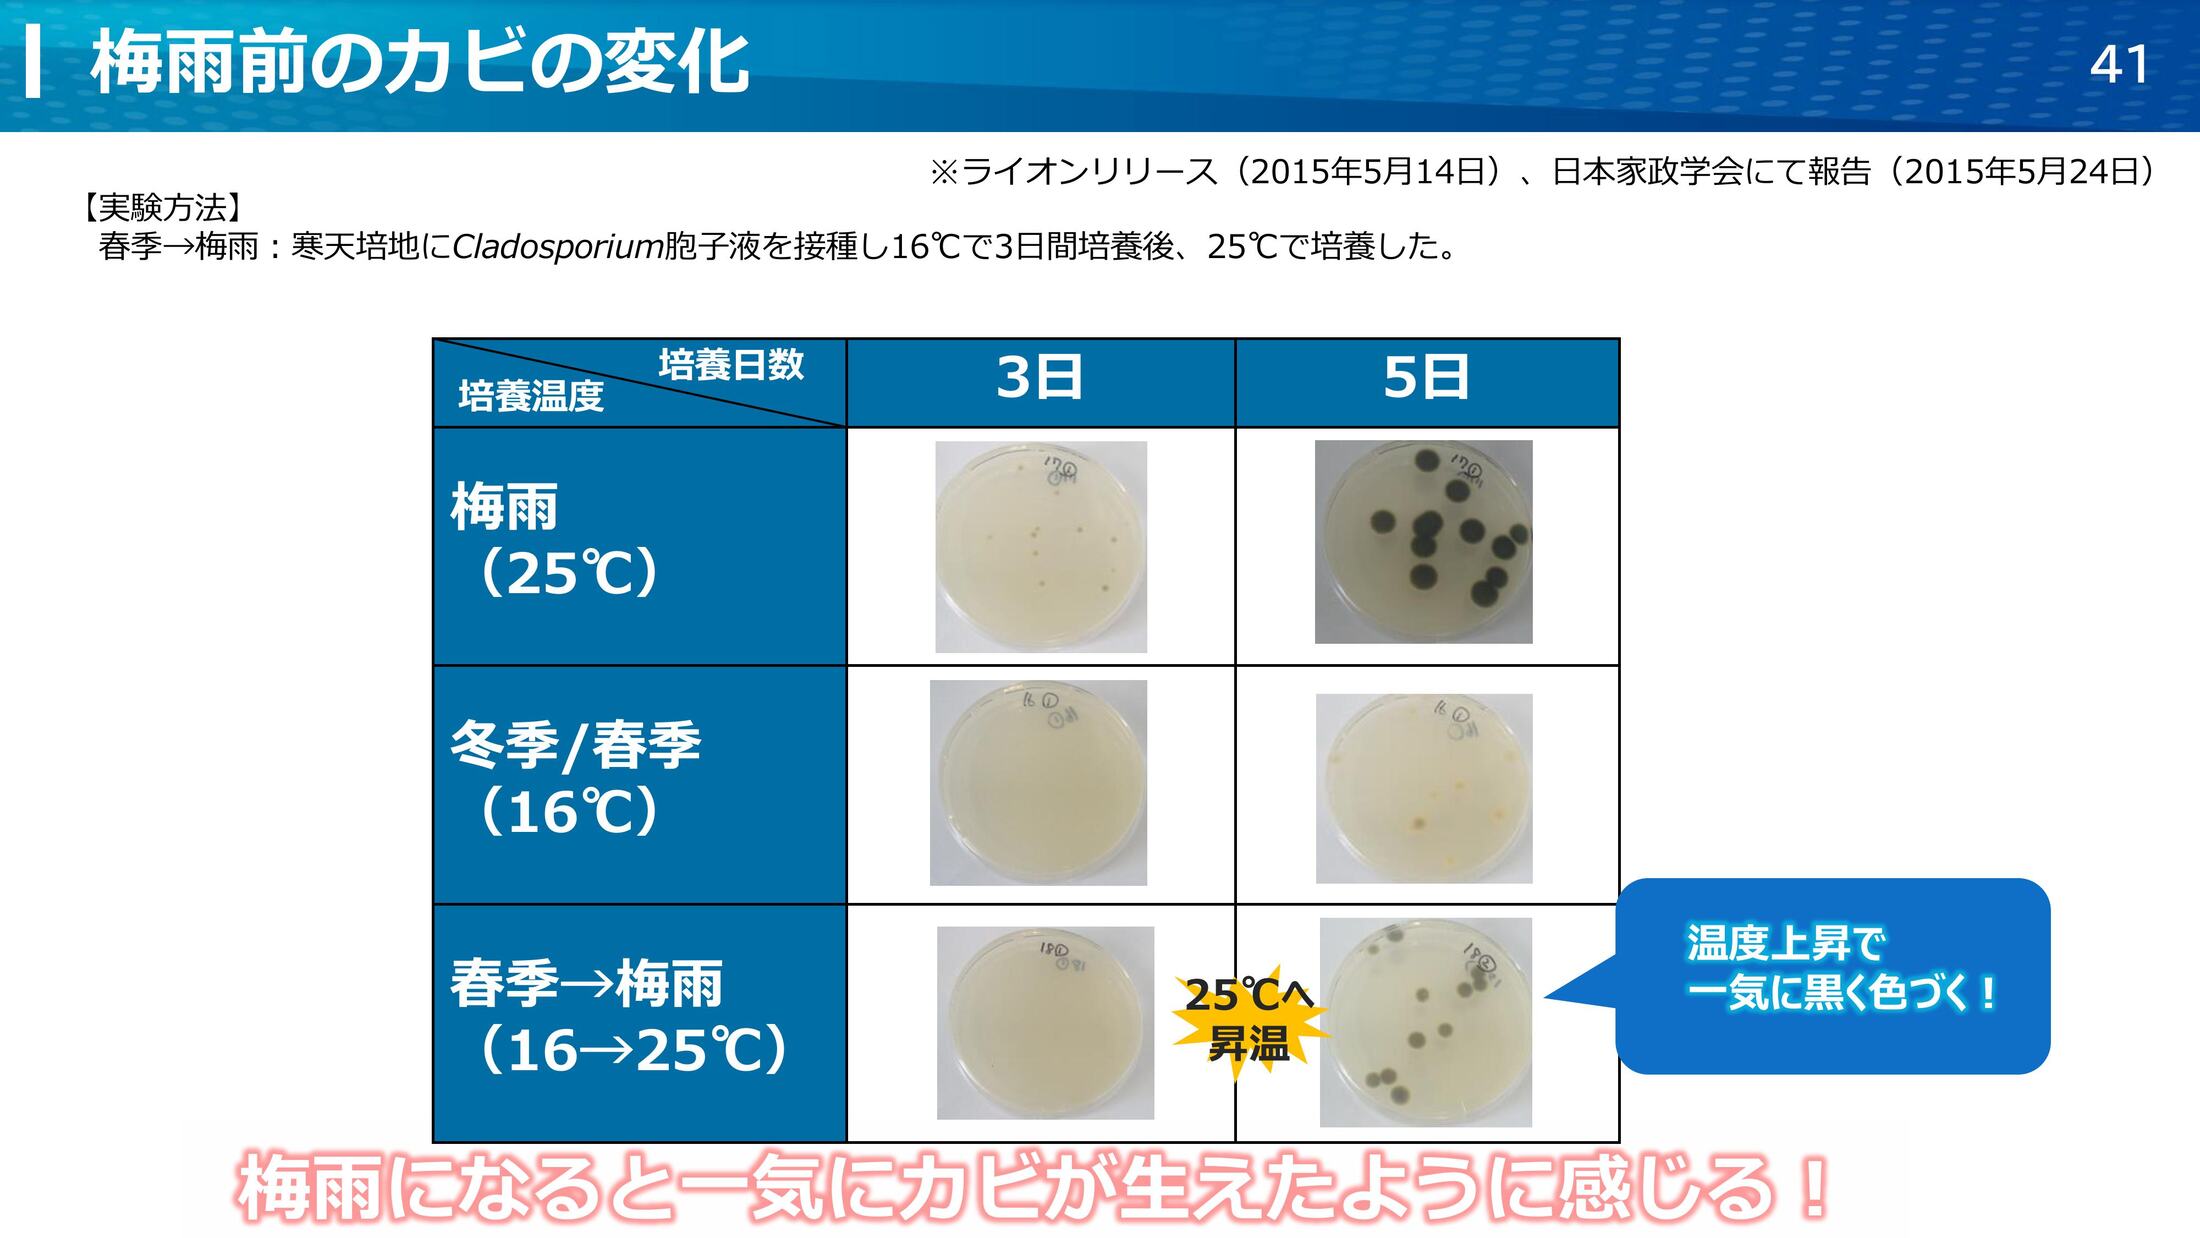
42

令和7年度 合同講演会 (2025.6.11)
ルックプラスおふろの防カビ くん煙剤の開発
ライオン株式会社 リビングケア研究所
溝田 志織

1/49

2/49

3/49

4/49

5/49

6/49

7/49

8/49

9/49

10/49

11/49

12/49

13/49

14/49

15/49

16/49

17/49

18/49

19/49

20/49

21/49

22/49

23/49

24/49

25/49

26/49

27/49

28/49

29/49

30/49

31/49

32/49

33/49

34/49

35/49

36/49

37/49

38/49

39/49

40/49

41/49

42/49

43/49

44/49

45/49

46/49

47/49

48/49

49/49